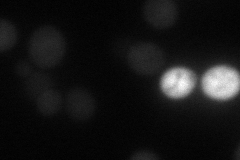
YDR403W

View description
Sporulation-specific enzyme required for spore wall maturation, involved in the production of a soluble LL-dityrosine-containing precursor of the spore wall; transcripts accumulate at the time of prospore enclosure
Localization:
Intensity:
Fold change:
Significance:
-
C’ GFP library in SD

below threshold13.38 -
N' NOP1pr-GFP in SD

cytosol106.596 -
N' TEF2pr-mCherry in SD
cytosol34.6051 -
N' NATIVEpr-GFP in SD

below threshold20.4142 -
N' TEF2pr-VC and Cyto-VN in SD

#N/A0 -
C’ GFP library in SD+DTT

cytosol15.991.19No -
C’ GFP library in SD+H2O2

cytosol13.91.03No -
C’ GFP library in Starvation Media

cytosol181.34No -
C’ GFP library on the background of Pup2-DaMP

below threshold -
C’ GFP library on the background of CCT mutant

below threshold16.77241.25273No
